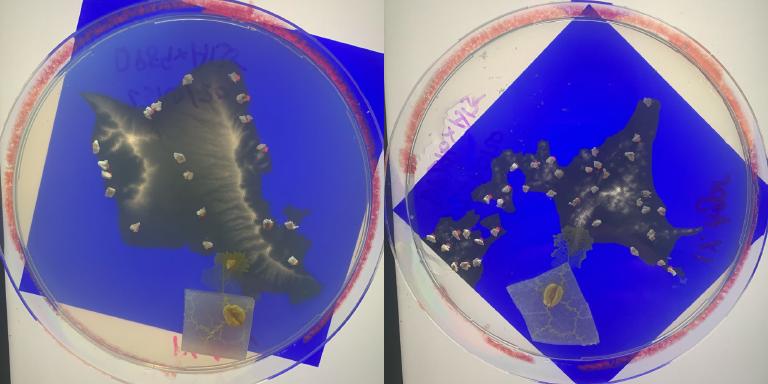
Slime mold network for Hokkaido and Hawaii

Optimizing transport networks using Physarum slime-mold
Overview
In a famous experiment by Tero et al. (2010), food sources were placed on agar plates in a pattern resembling cities in the Tokyo area. The researchers then introduced a Physarum Polycephalum slime mold onto the plate, which began consuming the food. Astoundingly, the pattern formed by the mold as it spread over the plate closely resembled the Tokyo railway system, which had been developed by civil engineers over decades.

Christian Sullivan, Eugene Sia and I recently conducted our own experiments on Physarum slime mold as part of

Non-neural intelligence
Physarum Polycephalum, a species of plasmodial slime mold, has been the subject of much scientific intrigue due to its ability to exhibit intelligent behavior without the presence of a nervous system. Through its ability to efficiently organize itself in search of food while avoiding deterrents, Physarum has demonstrated an array of seemingly cognitive capabilities such as:
- designing reversible logic gates (Schumann, 2017)
- approximating Voronoi diagrams (Jones, 2015)
- finding the shortest path in a maze (Nakagaki et al., 2000; Adamatzky, 2012a)
- solving the traveling salesman problems (Zhu et al., 2018)
- solving Steiner tree problems (Caleffi et al., 2015) in polynomial time (Zhu et al., 2018)
These results are truly peculiar, as they suggest that the organism’s ability to perform these tasks must stem from processes other than logical thought or instinct. In reality, Physarum’s seemingly intelligent behavior is an emergent property of the complex interactions between protoplasmic particles. Each particle obeys simple rules that depend on the dynamics of other particles. For example, in our algorithm, each simulated particle was programmed to follow the traces deposited by particles in front of it. This flow of information between the particles is similar to how neurons in the brain pass on electrical signals.
Conducting experiments on Physarum
Obtaining samples
Obtaining samples of the organism proved to be a relatively seamless process. We reached out to Chris Reid from Macquarie University, who connected us with a group of bio Ph.D. students at our uni. They generously provided us with a sample of over 20 strains of the organism, each cultured on a small rectangular agar cutout. A fascinating characteristic of Physarum is its ability to undergo binary fission, meaning that cutting the organism in half yields two identical copies of the original. As the organism is light-sensitive, I carefully transported the agar plates to my home and stored them in a dark cupboard. Physarum possesses a distinct odor, which is reminiscent of molten plastic.
Growing Physarum on agar plates
O‘ahu and Hokkaido were the ideal locations to put our algorithm to the test. Being self-contained islands with significant variations in elevation and population density, they provided the perfect opportunity to see how our model would compare to the networks formed by the actual biological organism. To mimic the location of towns, I meticulously placed small pieces of oat on the agar plates. To simulate mountainous areas and coastal regions, I applied a thin layer of salt water of varying concentrations, which served as a deterrent. Alternatively, one could have used a local light source.
Within only a few hours, some newly formed protoplasmic tubes had expanded beyond their original agar cutout. When the organism is in a state of starvation, it tends to form sparsely-connected, fast-growing tubes spanning long distances. On the other hand, when well-fed, the tubular network becomes significantly denser and highly connected. As food sources are depleted, the tubes become thinner and slowly fade away.
Physarum networks for O‘ahu and Hokkaido


The networks we observed varied significantly, possibly due to the use of different strains of Physarum. Despite this, most of the organisms formed efficient connections between all food sources, with some main tubes even overlapping with major, real-life highways and bridges. This was a testament to the organism’s innate ability to adapt and optimize its foraging strategy. Unfortunately, it became apparent that salt water failed to prevent the organism from traversing mountainous areas and entering the ocean. This was an unexpected outcome and it would be valuable for future researchers to explore alternative methods to control the organism’s movement. Overall, the experiment can be deemed a success, particularly given that it was only a minor part of the project.

Wrapping up the experiment

I kept the organism long after the primary experiment was over to assess how it would adapt to food scarcity. It eventually started climbing the walls of its agar plate and was able to escape. Shortly after, clumps (sporangia) started forming which eventually turned black as mature spores were released. I decided to ethically kill the organism by placing it in a sealed plastic bag and keeping it in the freezer for a couple of days.
Future research may focus on investigating the impact of strain and food scarcity on the foraging behavior of this organism, as well as evaluating the effectiveness of various chemical and physical deterrents.